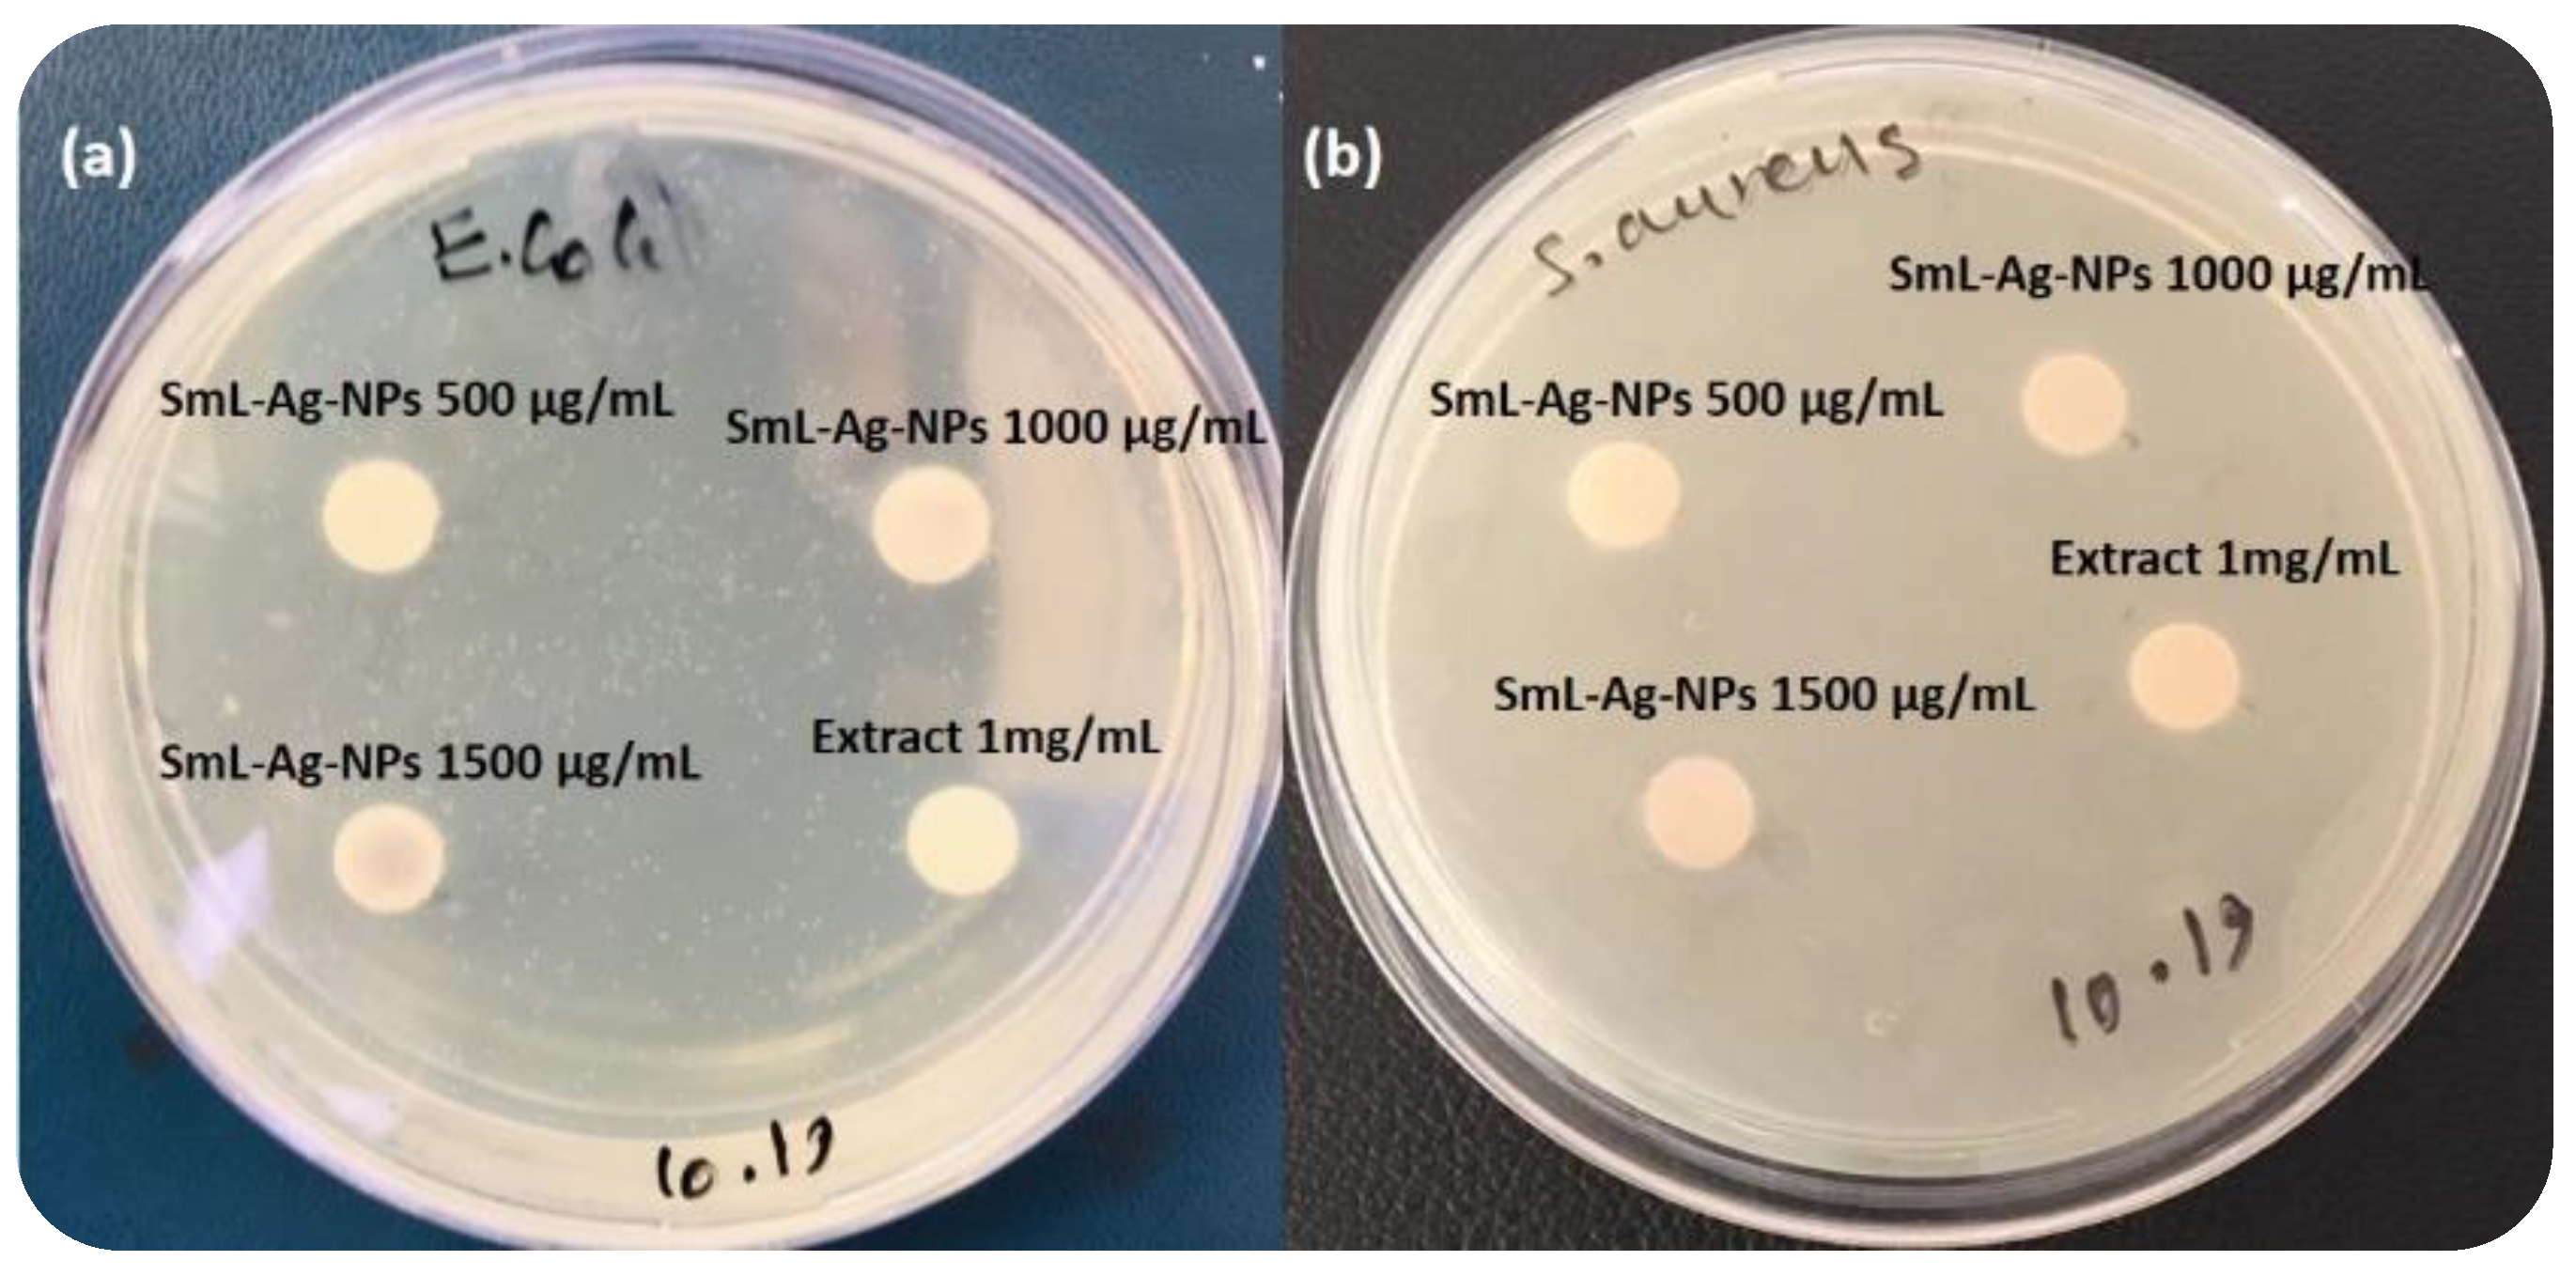
Pharmaceuticals 16 00992 g008

Eco-Friendly Green Synthesis and Characterization of Silver Nanoparticles by Scutellaria multicaulis Leaf Extract and Its Biological Activities
Abstract
1. Introduction
2. Results and Discussion
2.1. Biosynthesis and Characterization of SmL-Ag-NPs Using UV-Visible Spectroscopy Analysis
2.2. Field Emission Scanning Electron Microscope/Energy Dispersive X-ray (FE-SEM/EDX) Analysis of SmL-Ag-NPs
2.3. Size Distribution Analysis by Dynamic Light Scattering (DLS) Method
2.4. Zeta Potential (ζ) Measurement of SmL-Ag-NPs
2.5. Thermal Stability Analysis of SmL-Ag-NPs Using Thermogravimetric Analysis (TGA) and Derivative Thermogravimetry (DTG)
2.6. Surface-Enhanced Raman Scattering (SERS) Analysis of SmL-Ag-NPs
2.7. X-ray Crystallography (XRD) Analysis of SmL-Ag-NPs
2.8. Fourier Transform Infrared Spectroscopic (FTIR) Analysis
2.9. Phytochemical Composition Assay of SmL-Ag-NPs and S. multicaulis Leafs Extract
2.10. Antioxidant Activity of S. multicaulis Leaf Extract-Mediated Synthesized SmL-Ag-NPs
2.11. Antibacterial Activity of SmL-Ag-NPs
2.12. Cytotoxicity of SmL-Ag-NPs against MDA-MB231 Cells
2.13. Apoptotic Effect of SmL-Ag-NPs on MDA-MB231 and HFF2 Cells
3. Materials and Methods
3.1. Collection of Plant Material and Preparation of Plant Extract
3.2. Biosynthesis and Characterization of SmL-Ag-NPs Using S. multicaulis Leaf Extract
3.3. Characterization of Biosynthesized SmL-Ag-NPs
3.4. Phytochemical Composition, Antioxidant Potential, and Antimicrobial Activity of SmL-Ag-NPs
3.5. In Vitro Cell Viability Assay of MDA-MB231 and HFF2 Cells Treated with SmL-Ag-NPs
3.6. Cell Apoptotic Effect of SmL-Ag-NPs
3.7. Statistical Analysis
4. Conclusions
Author Contributions
Funding
Institutional Review Board Statement
Informed Consent Statement
Data Availability Statement
Conflicts of Interest
References
- Kreso, A.; O’Brien, C.A.; Van Galen, P.; Gan, O.I.; Notta, F.; Brown, A.M.K.; Ng, K.; Ma, J.; Wienholds, E.; Dunant, C.; et al. Variable clonal repopulation dynamics influence chemotherapy response in colorectal cancer. Science 2013, 339, 543–548. [Google Scholar] [CrossRef]
- Jin, C.; Wang, K.; Oppong-Gyebi, A.; Hu, J. Application of nanotechnology in cancer diagnosis and therapy—A mini-review. Int. J. Med. Sci. 2020, 17, 2964–2973. [Google Scholar] [CrossRef]
- Simon, S.; Sibuyi, N.R.S.; Fadaka, A.O.; Meyer, S.; Josephs, J.; Onani, M.O.; Meyer, M.; Madiehe, A.M. Biomedical Applications of Plant Extract-Synthesized Silver Nanoparticles. Biomedicines 2022, 10, 2792. [Google Scholar] [CrossRef] [PubMed]
- Gharari, Z.; Hanachi, P.; Sadeghinia, H.; Walker, T.R. Cichorium intybus bio-callus synthesized silver nanoparticles: A promising antioxidant, antibacterial and anticancer compound. Int. J. Pharm. 2022, 625, 122062. [Google Scholar] [CrossRef]
- Gong, D.; Sun, L.; Li, X.; Zhang, W.; Zhang, D.; Cai, J. Micro/Nanofabrication, Assembly, and Actuation Based on Microorganisms: Recent Advances and Perspectives. Small Struct. 2023, 2200356. [Google Scholar] [CrossRef]
- Pokrajac, L.; Abbas, A.; Chrzanowski, W.; Dias, G.M.; Eggleton, B.J.; Maguire, S.; Maine, E.; Malloy, T.; Nathwani, J.; Nazar, L.; et al. Nanotechnology for a sustainable future: Addressing global challenges with the international network4sustainable nanotechnology. ACS Nano 2021, 15, 18608–18623. [Google Scholar] [CrossRef] [PubMed]
- Gharari, Z.; Hanachi, P.; Walker, T.R. Green synthesized Ag-nanoparticles using Scutellaria multicaulis stem extract and their selective cytotoxicity against breast cancer. Anal. Biochem. 2022, 653, 114786. [Google Scholar] [CrossRef]
- Zhang, X.-F.; Liu, Z.-G.; Shen, W.; Gurunathan, S. Silver nanoparticles: Synthesis, characterization, properties, applications, and therapeutic approaches. Int. J. Mol. Sci. 2016, 17, 1534. [Google Scholar] [CrossRef]
- Govaerts, R. World Checklist of Selected Plant Families Database in ACCESS: 1-216203; The Board of Trustees of the Royal Botanic Gardens: Kew, UK, 2003. [Google Scholar] [CrossRef]
- Gharari, Z.; Bagheri, K.; Khodaeiaminjan, M.; Sharafi, A. Potential therapeutic effects and bioavailability of wogonin, the flavone of Baikal skullcap. J. Nutr. Med. Diet Care 2019, 5, 039. [Google Scholar] [CrossRef]
- Gharari, Z.; Bagheri, K.; Danafar, H.; Sharafi, A. Chemical Composition and Antimicrobial Activity of Scutellaria araxensis Essential Oil from Iran. Chem. Nat. Compd. 2020, 56, 745–747. [Google Scholar] [CrossRef]
- Gharari, Z.; Aghajanzadeh, M.; Sharafi, A. Scutellaria orientalis subsp. Bornmuelleri: Phytochemical composition and biological activities. Nat. Prod. Res. 2022, 36, 1385–1390. [Google Scholar] [CrossRef] [PubMed]
- Chen, L.; Huo, Y.; Han, Y.X.; Li, J.F.; Ali, H.; Batjikh, I.; Hurh, J.; Pu, J.Y.; Yang, D.C. Biosynthesis of gold and silver nanoparticles from Scutellaria baicalensis roots and in vitro applications. Appl. Phys. A 2020, 126, 424. [Google Scholar] [CrossRef]
- Shermatova, I.B.; Ismailova, M.G. Obtaining and Studying Technology of Dry Substance Silver Nanoparticles Obtained by “Green Synthesis” Method Using Scutellaria Iscandaria L. Indian J. Forensic Med. Toxicol. 2020, 14, 7624–7635. [Google Scholar] [CrossRef]
- Ismailova, M.; Shermatova, I.; Ismailova, P.; Ishimov, U. Study of the role of some Scutellaria Iscandaria L. extract’s flavonoids on nanosilver synthesis. World J. Pharm. Res. 2020, 8, 19–25. [Google Scholar]
- Veeraraghavan, V.P.; Periadurai, N.D.; Karunakaran, T.; Hussain, S.; Surapaneni, K.M.; Jiao, X. Green synthesis of silver nanoparticles from aqueous extract of Scutellaria barbata and coating on the cotton fabric for antimicrobial applications and wound healing activity in fibroblast cells (L929). Saudi J. Biol. Sci. 2021, 28, 3633–3640. [Google Scholar] [CrossRef]
- Giaquinto, A.N.; Sung, H.; Miller, K.D.; Kramer, J.L.; Newman, L.A.; Minihan, A.; Jemal, A.; Siegel, R.L. Breast cancer statistics, 2022. CA Cancer J. Clin. 2022, 72, 524–541. [Google Scholar] [CrossRef]
- Hanachi, P.; Gharari, Z.; Sadeghinia, H.; Walker, T.R. Synthesis of Bioactive Silver Nanoparticles with Eco-Friendly Processes Using Heracleum persicum Stem Extract and Evaluation of Their Antioxidant, Antibacterial, Anticancer and Apoptotic Potential. J. Mol. Struct. 2022, 1265, 133325. [Google Scholar] [CrossRef]
- Jadhav, K.; Deore, S.; Dhamecha, D.; Rajeshwari, R.H.; Jagwani, S.; Jalalpure, S.; Bohara, R. Phytosynthesis of silver nanoparticles: Characterization, biocompatibility studies, and anticancer activity. ACS Biomater. Sci. Eng. 2018, 4, 892–899. [Google Scholar] [CrossRef]
- Aglin, A.; Shruthi, P.; Subathra, S. Selective Toxicity of Biosynthesised Silver Nanoparticles on MCF-7 and MDA MB-231 Breast Cancer Cell Lines. Int. J. ChemTech Res. 2019, 12, 7–16. [Google Scholar] [CrossRef]
- Sun, Q.; Cai, X.; Li, J.; Zheng, M.; Chen, Z.; Yu, C.-P. Green synthesis of silver nanoparticles using tea leaf extract and evaluation of their stability and antibacterial activity. Colloids Surf. A Physicochem. Eng. Asp. 2014, 444, 226–231. [Google Scholar] [CrossRef]
- Liu, J.; Yang, T.; Li, C.; Dai, J.; Han, Y. Reversibly switching silver hierarchical structures via reaction kinetics. Sci. Rep. 2015, 5, 14942. [Google Scholar] [CrossRef]
- Vatansever, F.; Hamblin, M.R. Surface-initiated polymerization with poly (n-hexylisocyanate) to covalently functionalize silica nanoparticles. Macromol. Res. 2017, 25, 97–107. [Google Scholar] [CrossRef]
- Wong, C.S.; Badri, K.H. Chemical analyses of palm kernel oil-based polyurethane prepolymer. Mater. Sci. Appl. 2012, 3, 78–81. [Google Scholar] [CrossRef]
- Aboyewa, J.A.; Sibuyi, N.R.S.; Meyer, M.; Oguntibeju, O.O. Green synthesis of metallic nanoparticles using some selected medicinal plants from southern africa and their biological applications. Plants 2021, 10, 1929. [Google Scholar] [CrossRef] [PubMed]
- Aboyewa, J.A.; Sibuyi, N.R.S.; Meyer, M.; Oguntibeju, O.O. Gold nanoparticles synthesized using extracts of Cyclopia intermedia, commonly known as honeybush, amplify the cytotoxic effects of doxorubicin. Nanomaterials 2021, 11, 132. [Google Scholar] [CrossRef] [PubMed]
- Majoumouo, M.S.; Sharma, J.R.; Sibuyi, N.R.S.; Tincho, M.B.; Boyom, F.F.; Meyer, M. Synthesis of biogenic gold nanoparticles from Terminalia mantaly extracts and the evaluation of their in vitro cytotoxic effects in cancer cells. Molecules 2020, 25, 4469. [Google Scholar] [CrossRef]
- Saumya, S.M.; Basha, P.M. Antioxidant effect of Lagerstroemia speciosa Pers (Banaba) leaf extract in streptozotocin-induced diabetic mice. Indian J. Exp. Biol. 2011, 49, 125–131. [Google Scholar]
- Bapat, R.A.; Chaubal, T.V.; Joshi, C.P.; Bapat, P.R.; Choudhury, H.; Pandey, M.; Gorain, B.; Kesharwani, P. An overview of application of silver nanoparticles for biomaterials in dentistry. Mater. Sci. Eng. C 2018, 91, 881–898. [Google Scholar] [CrossRef]
- Khorrami, S.; Zarrabi, A.; Khaleghi, M.; Danaei, M.; Mozafari, M.R. Selective cytotoxicity of green synthesized silver nanoparticles against the MCF-7 tumor cell line and their enhanced antioxidant and antimicrobial properties. Int. J. Nanomed. 2018, 13, 8013–8024. [Google Scholar] [CrossRef] [PubMed]
- Yin, I.X.; Zhang, J.; Zhao, I.S.; Mei, M.L.; Li, Q.; Chu, C.H. The antibacterial mechanism of silver nanoparticles and its application in dentistry. Int. J. Nanomed. 2020, 15, 2555–2562. [Google Scholar] [CrossRef] [PubMed]
- Wahab, S.; Khan, T.; Adil, M.; Khan, A. Mechanistic aspects of plant-based silver nanoparticles against multi-drug resistant bacteria. Heliyon 2021, 7, E07448. [Google Scholar] [CrossRef] [PubMed]
- Lin, W.; Huang, Y.-w.; Zhou, X.-D.; Ma, Y. In vitro toxicity of silica nanoparticles in human lung cancer cells. Toxicol. Appl. Pharmacol. 2006, 217, 252–259. [Google Scholar] [CrossRef]
- Henslee, E.A.; Serrano, R.M.T.; Labeed, F.H.; Jabr, R.I.; Fry, C.H.; Hughes, M.P.; Hoettges, K.F. Accurate quantification of apoptosis progression and toxicity using a dielectrophoretic approach. Analyst 2016, 141, 6408–6415. [Google Scholar] [CrossRef] [PubMed]
- Ullah, I.; Khalil, A.T.; Ali, M.; Iqbal, J.; Ali, W.; Alarifi, S.; Shinwari, Z.K. Green-synthesized silver nanoparticles induced apoptotic cell death in MCF-7 breast cancer cells by generating reactive oxygen species and activating caspase 3 and 9 enzyme activities. Oxidative Med. Cell. Longev. 2020, 2020, 1215395. [Google Scholar] [CrossRef]
- Forman, H.J.; Torres, M. Reactive oxygen species and cell signaling: Respiratory burst in macrophage signaling. Am. J. Respir. Crit. Care Med. 2002, 166, S4–S8. [Google Scholar] [CrossRef] [PubMed]
- Gurunathan, S.; Han, J.W.; Eppakayala, V.; Jeyaraj, M.; Kim, J.-H. Cytotoxicity of biologically synthesized silver nanoparticles in MDA-MB-231 human breast cancer cells. BioMed Res. Int. 2013, 2013, 535796. [Google Scholar] [CrossRef]
- Hsin, Y.-H.; Chen, C.-F.; Huang, S.; Shih, T.-S.; Lai, P.-S.; Chueh, P.J. The apoptotic effect of nanosilver is mediated by a ROS- and JNK-dependent mechanism involving the mitochondrial pathway in NIH3T3 cells. Toxicol. Lett. 2008, 179, 130–139. [Google Scholar] [CrossRef] [PubMed]
- Charghadchi, M.; Gharari, Z.; Sadighian, S.; Yazdinezhad, A.; Sharafi, A. Green Synthesized Silver Nanostructure Using Rhus coriaria Fruit Extract Inhibits the Growth of Malignant MCF-7 Cell Line. Braz. Arch. Biol. Technol. 2022, 64, e21210069. [Google Scholar] [CrossRef]

Disclaimer/Publisher’s Note: The statements, opinions and data contained in all publications are solely those of the individual author(s) and contributor(s) and not of MDPI and/or the editor(s). MDPI and/or the editor(s) disclaim responsibility for any injury to people or property resulting from any ideas, methods, instructions or products referred to in the content. |
© 2023 by the authors. Licensee MDPI, Basel, Switzerland. This article is an open access article distributed under the terms and conditions of the Creative Commons Attribution (CC BY) license (https://creativecommons.org/licenses/by/4.0/).
Share and Cite
Gharari, Z.; Hanachi, P.; Sadeghinia, H.; Walker, T.R. Eco-Friendly Green Synthesis and Characterization of Silver Nanoparticles by Scutellaria multicaulis Leaf Extract and Its Biological Activities. Pharmaceuticals 2023, 16, 992. https://doi.org/10.3390/ph16070992
Gharari Z, Hanachi P, Sadeghinia H, Walker TR. Eco-Friendly Green Synthesis and Characterization of Silver Nanoparticles by Scutellaria multicaulis Leaf Extract and Its Biological Activities. Pharmaceuticals. 2023; 16(7):992. https://doi.org/10.3390/ph16070992
Chicago/Turabian StyleGharari, Zahra, Parichehr Hanachi, Hanie Sadeghinia, and Tony R. Walker. 2023. "Eco-Friendly Green Synthesis and Characterization of Silver Nanoparticles by Scutellaria multicaulis Leaf Extract and Its Biological Activities" Pharmaceuticals 16, no. 7: 992. https://doi.org/10.3390/ph16070992
APA StyleGharari, Z., Hanachi, P., Sadeghinia, H., & Walker, T. R. (2023). Eco-Friendly Green Synthesis and Characterization of Silver Nanoparticles by Scutellaria multicaulis Leaf Extract and Its Biological Activities. Pharmaceuticals, 16(7), 992. https://doi.org/10.3390/ph16070992









